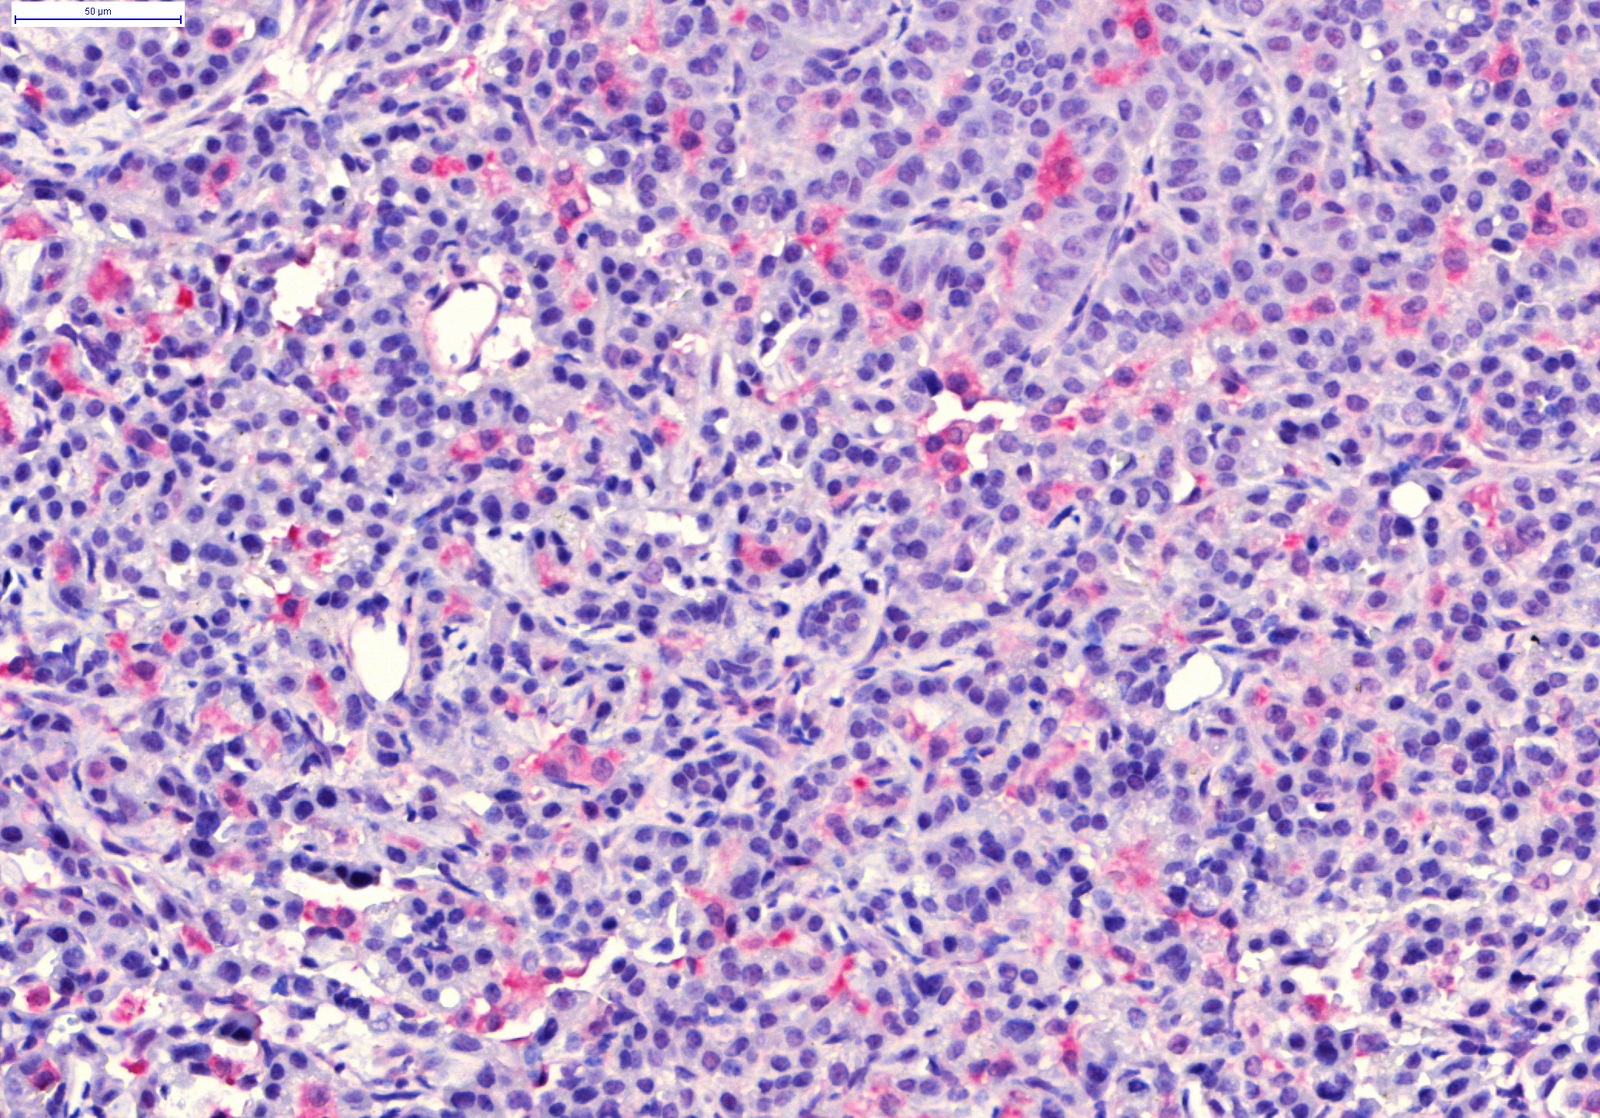

Akciğer kanseri dünyadaki bu tür hastalık kaynaklı ölümlerin en yaygın nedenlerinden birincisi.
Yılda 1,76 milyon kişi akçiğer kanserinden dolayı yaşamını yitiriyor.
Hastalıktan dolayı gerçekleşen ölümlerin önüne geçilmesi için bilimsel çalışmalar yapılıyor.
Bu çalışmalarda yer alanlardan biri de Türk doktor Deniz Ali Bölükbaş.
Bölükbaş, Almanya'da Helmholtz-Zentrum München ortaklığıyla Münih Ludwig Maximilian Üniversitesi'nde Experimental Pneumology bölümünde akciğer kanseri deneysel tanı ve tedavisi üzerine doktora yaptı.
Bölükbaş, doktora sonrası araştırmalarını İsveç Lund Üniversitesi Tıp Fakültesi'nde akut ve kronik solunum yolu hastalıkları ve rejenerasyonu üzerine yürütüyor.
Lisans eğitimini Hacettepe Üniversitesi'nde tamamladıktan sonra yüksek lisans eğitimini Almanya'da RWTH Aachen Üniversitesi'nde tamamlayan Dr. Bölükbaş, NIM (Nanosystems Initiative Munich) tarafından desteklenen kanser teşhisi ve tedavisi üzerine yoğunlaşan doktora çalışmalarına Münih'te devam etti.
Akciğer kanseri için hem erken tanı hem de nanotıp bazlı tedaviler üzerine çalışmalar yapan Bölükbaş, bu alanda yürütülen bilimsel çalışmalar hakkında bilgi verdi.
Bölükbaş, akciğer kanserinin genelde geç evrede tespit edildiğini ve bu nedenle tedavi şansının azaldığını söyledi.
"Klasik röntgen gibi hızlı fakat daha detaylı bilgi sunabilen bir teknik geliştirdik" diyen Bölükbaş, "İlk kez kanser dokusunun görüntülenmesinde kullandık. X-ray Dark-field imaging adı verilen görüntüleme yöntemi Scientific Reports Dergisi'nde yayınlandı. Sadece akciğer için değil başka organlarda da görüntüleme amaçlı kullanılabilecek bu teknik, şu an klinik çalışma aşamasında devam ediyor" dedi.
"Nanotıp, akciğer kanseri tedavisi için hedefli ve kontrollü ilaç dağıtımını mümkün kılıyor"
Geç tanı konmuş, metastaz yapmış diğer dokulara ve organlara yayılmış, kanserin tedavisi için en sık başvurulan yöntemin kemoterapi olduğunu savunan Bölükbaş, "Ne yazık ki kemoterapi sadece kanser hücrelerini hedeflemiyor ve vücuttaki bazı sağlıklı dokulara da zarar veriyor. Yine yan etkilerden ötürü hastalar sıkıntılı bir dönem geçiriyor. Bazen bu problemleri en aza indirmek için kemoterapinin dozunu düşürmek gerekebiliyor" diye konuştu.
Nanotıp bazlı tedavilerin ise nanoteknolojinin gelişmesi ile şu ana kadar mümkün olmayan ilaç tasarımlarını tıpta tanı ve tedavi için kullanılmasına olanak sağladığını vurgulayan Dr. Bölükbaş, "Nano boyutlu ilaçların avantajı hem hücre ile etkileşime girebilecek kadar küçük olmaları hem de istenilen tasarımların laboratuvar ortamında en ince ayrıntısıyla üretilebilmesi" ifadelerini kullandı.
Nanoparçacık bazlı tedavilerin, artan terapötik etkinlik ve azaltılmış sistemik toksisite ile akciğer kanseri tedavisi için hedefli ilaç dağıtımını mümkün kılıdığını belirten Dr. Bölükbaş, şunları söyledi:
Aynı zamanda nanotıp, akciğer tümörünün multimodal tedavisi için, tümörle ilişkili birkaç hücre tipinin aynı zamanda ve bölgesel olarak kontrollü bir şekilde hedeflemesini içerebilecek potansiyele sahip. Kanser hücreleri ve içinde bulundukları ortam (ekstraselüler matriks) kanserin daha fazla yayılabilmesi için diğer sağlıklı hücrelerden ve matrikslerden farklı özelliklere sahipler. Bu özellikleri moleküler ve genetik düzeyde teşhis edip tasarladığımız ajanların bu farkları spesifik olarak hedeflemelerini ve ilaç salınımlarını amaçlıyoruz.
Ayrıca nanaotıpın, tümör dokusunu ele geçiren kanser hücreleri çevrelerindeki eskiden sağlıklı olan hücreleri de kendi avantajlarına kullanmak için etken maddeler salgıladığını da aktaran Dr. Bölükbaş, "Bunun sonucunda, örneğin bağışıklık sistemi hücreleri asıl görevlerini unutup kanserin yayılmasına yardım etmeye başlıyorlar. Bizim tasarımlarımızdaki ufak değişikliklerle aynı anda bu farklı tipteki hücre tiplerini hedefleyebiliyoruz. Böylece daha etkili bir tedavi elde etmeyi hedefliyoruz" değerlendirmesinde bulundu.
Nanotıp ajanlarının son yıllarda oldukça yaygın bir şekilde araştırılıp geliştirildiğini dile getiren Bölükbaş, şunlaır kaydetti:
"Günümüzde klinik olarak kullanımda olan birçok ajan da var. Fakat yine de akademik ortamda oldukça başarı gösteren çalışmaların klinik başarıları beklenilenden daha yavaş oluyor. Çoğu tasarım laboratuvar ortamında başarı gösterirken klinik çalışmalarda aynı başarıyı sağlayamıyor. Bunun başlıca nedenlerinden bir tanesi, laboratuvar çalışmalarının birçoğunun gerçeküstü modellerde ilaçları geliştiriyor olması. Örneğin bağışıklık sistemi bastırılmış fare modellerinde."
Fare akciğerinde operasyon sırasında mikroskoptan görüntü
"Gerçek hayatta ise bu ajanların vücuda girer girmez vücuttaki savunma mekanizmalarına karşı koyup tümör dokusuna ulaşmaları gerekiyor" diyen Dr. Bölükbaş, sözlerini şöyle sürdürdü:
Biz çalışmalarımızda, fare boyutunda da olsa, bunu göz önünde bulundurarak gerçeğe en yakın modelleri tercih ediyoruz. Birçok nano ajan kan yoluyla enjekte edildiğinde hedefi başka bir organ olsa bile özelliklerine göre ya vücuttan atılıyor ya da toksik madde olarak algılanıp karaciğerde kendini buluyor. Kendi tasarımımızın da önce bu problemle karşılaştığını gösterdikten sonra bunun üstesinden gelmek için nanoparçacıklarımızı akciğere lokal yoldan enjekte etmeyi ve akciğer kan dolaşımını bu süreçte izole etmeyi denedik.
"Yöntemimiz sadece akciğer dolaşımını hedeflediği için diğer organları da etkilemiyor"
Günümüzde birçok nano bazlı ajanların hedefli tedavi yöntemleri ya da tanı amaçlı olarak kullanıma girdiğini ve birçoğunun ise hala klinik deney aşamasında olduğunu belirten Bölükbaş, "Bizim son yayımlanan çalışmamız mezoporoz silika nanoparçacıkları kullanarak akciğer kanseri tedavisindeki etkilerini görmeyi amaçlıyordu" dedi.
Çalışmanın ayırt edici tarafının, klinikte hali hazırda kullanılan fakat kemoterapinin sağlıklı akciğer dokusuna aşırı yan etkisinden dolayı çok da başvurulmayan bir tekniği (isolated lung perfusion) nanotıp bazlı bir ajanla ilk kez kullanmış olmaları olarak açıklayan Bölükbaş, şöyle devam etti:
Nanoparçacıklarımızın sadece kanser dokusunda toplandığını gösterdik. Üstelik yöntemimiz sadece akciğer dolaşımını hedeflediği için diğer organları da etkilemiyor. Böylece kemoterapiyi sadece kanser hücrelerine yansıtma fırsatımız doğuyor, yani normalde kemoterapiden zarar görecek sağlıklı hücrelere ilaç negatif etki etmeyecek. Şimdiki hedefimiz şu ana kadar sadece fare modellerinde kanıtladığımız bu etkiyi büyük hayvan modellerinde denemek.
"Yoğun bakımdaki hastalarda akciğerdeki durumun iyiye ya da kötüye gittiğini hastadan alınan nefes örneklerinden okumayı hedefliyoruz"
Kansere paralel olarak deneysel ARDS (akut solunum sikintisi sendromu) çalışmalarının da devam ettiğini söyleyen Bölükbaş, "Kovid-19'da da görüldüğü gibi sitokin fırtınasını modellediğimiz ve tanısında yeni teknolojileri denediğimiz bir çalışmamız yayımlandı. Bu çalışma ve gelecek çalışmalarımızda yoğun bakımda mekanik ventilasyon ya da ECMO gören hastalarda akciğerdeki durumun iyiye ya da kötüye gittiğini hastadan alınan nefes örneklerinden okumayı hedefliyoruz" diye konuştu.
Daha lokal ve dolayısıyla akciğerdeki durumu daha spesifik özetleyen nefes analizinin, şu an ARDS tanısı ve ilerleyişinde kullanılan kan ölçümlerinden daha erken bilgi sağlayabilieceğine dikkat çeken Bölükbaş, "Henüz yeni olan bu tekniğin başarısı klinik testlerde değerlendiriliyor. Fakat analiz yöntemleri ve sonuçlarının hızla değerlendirilebilmesi ve bu tekniğin rutin kullanıma elverişli olabilmesi için çalışmalar devam ediyor" dedi.
"KOAH için laboratuvarda kök hücre tedavisini deniyoruz"
İsveç Vinnova bursu alarak devam ettiği bir çalışmasının da KOAH (Kronik Obstrüktif Akciğer Hastalığı) tedavisi üzerine olduğunu dile getiren Bölükbaş, şunları söyledi:
KOAH da dünyada ve ülkemizde oldukça yaygın bir hastalık, dünyada yılda 3 milyonun üzerinde ölüme neden oluyor. Ne yazık ki bu hastalık için günümüzde kullanılan ilaçlar hastalığı iyileştiremiyor ve sadece hastalığın ilerlemesini durdurmayı ya da yavaşlatmayı amaçlıyor. Hastalığın tek çözümü akciğer nakli, fakat ne yazık ki yeterli akciğer donörü yok. Ayrıca akciğer nakli diğer organ nakillerine kıyasla başarısı en düşük olanı. Vücudun organa karşı tepki göstermemesi için bağışıklığı bastıran ajanlar kullanılıyor ve bu da hastaların enfeksiyon riskini artırıyor. KOAH için laboratuvarda kök hücre tedavisini deniyoruz.
Akciğerin, vücuttaki diğer dokulara kıyasla oldukça yavaş kendini yenileme ve iyileştirme özelliğine sahip olduğuna dikkati çeken Dr. Bölükbaş, "Bu yenilenmeye farklı tipte kök hücre tedavilerinin lokal ve organ bazında faydalı etkilerinin olacağını düşünüyoruz. Bu çalışmalarımızı da yine hayvan ve insan dokusu üzerinde yoğunlaştırıyoruz" ifadelerini kullandı.
Dr. Bölükbaş, şu bilgileri verdi:
"Bunun dışında diğer çalışmalarımızda doku mühendisliği teknikleri kullanarak laboratuvar ortamında hem akciğer nakline yardımcı olabilecek nitelikte fonksiyonel akciğer dokusu üretmeye hem de laboratuvar ortamında hastalık modelleri oluşturarak bu modelleri patofizyolojik mekanizmaları ve tedavi yöntemlerini araştırmak için moleküler ve hücre düzeyinde çalışıyoruz . Bunu gerçekleştirirken hem doğal (biyolojik kaynaklı) hem de sentetik malzemeleri kullanıyoruz."
© The Independentturkish